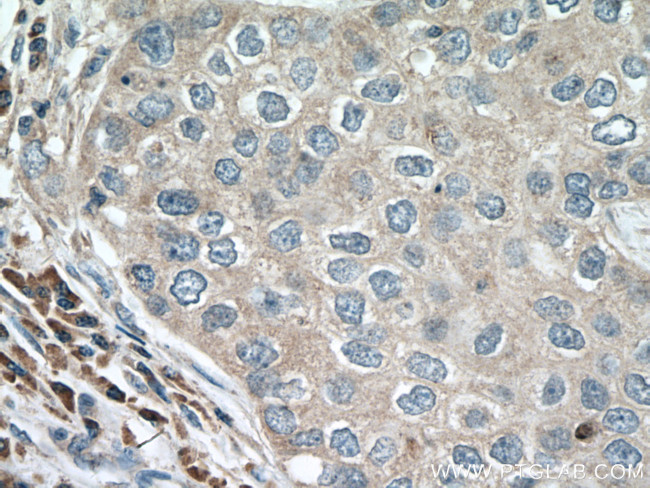
ACAP1 Antibody in Immunohistochemistry (Paraffin) (IHC (P))

Search
Proteintech
ACAP1 Monoclonal Antibody (1B4C9)
{{$productOrderCtrl.translations['antibody.pdp.commerceCard.promotion.promotions']}}
{{$productOrderCtrl.translations['antibody.pdp.commerceCard.promotion.viewpromo']}}
{{$productOrderCtrl.translations['antibody.pdp.commerceCard.promotion.promocode']}}: {{promo.promoCode}} {{promo.promoTitle}} {{promo.promoDescription}}. {{$productOrderCtrl.translations['antibody.pdp.commerceCard.promotion.learnmore']}}
产品信息
66596-1-IG
种属反应
宿主/亚型
分类
类型
克隆号
抗原
偶联物
形式
浓度
纯化类型
保存液
内含物
保存条件
运输条件
产品详细信息
Immunogen sequence: SIELVEAEV SELETRLEKL LKLGTGLLES GRHYLAASRA FVVGICDLAR LGPPEPMMAE CLEKFTVSLN HKLDSHAELL DATQHTLQQQ IQTLVKEGLR GFREARRDFW RGAESLEAAL THNAEVPRRR AQEAEEAGAA LRTARAGYRG RALDYALQIN VIEDKRKFDI MEFVLRLVEA QATHFQQGHE ELSRLSQYRK ELGAQLHQLV LNSAREKRDM EQRHVLLKQK ELG (20-251 aa encoded by BC018543)
靶标信息
ACAP1, also known as Centaurin-beta-1 (CENTB1), is a 740 amino acid containing transport carrier belonging to the Centaurin family with three ANK repeats, an Arf-GAP domain, a BAR domain and a PH domain that binds to phospholipids. ACAP1, a GTPase-activating protein (GAP) for ADP ribosylation factor 6 (ARF6), is required for clathrin-dependent export of proteins from recycling endosomes to trans-Golgi network and cell surface. It mediates CENTB1-binding to phosphatidylinositol 3,5-bisphosphate (PIP2) or phosphatidylinositol 3,4,5-trisphosphate (PIP3) containing membranes. Along with ACAP2, ACAP1 is recruited to platelet-derived growth factor (PDGF) induced dorsal membrane ruffles in NIH 3T3 mouse fibroblasts, while over expression inhibited ruffle formation. It is widely expressed in most tissues with high expression in lung and spleen and low expression in heart, kidney, liver and pancreas.
仅用于科研。不用于诊断过程。未经明确授权不得转售。
生物信息学
蛋白别名: Arf GAP with coiled coil, ANK repeat and PH domains 1; Arf-GAP with coiled-coil, ANK repeat and PH domain-containing protein 1; centaurin beta 1; centaurin, beta 1; Centaurin-beta-1; Cnt-b1
基因别名: ACAP1; CENTB1; KIAA0050
UniProt ID: (Human) Q15027
Entrez Gene ID: (Human) 9744